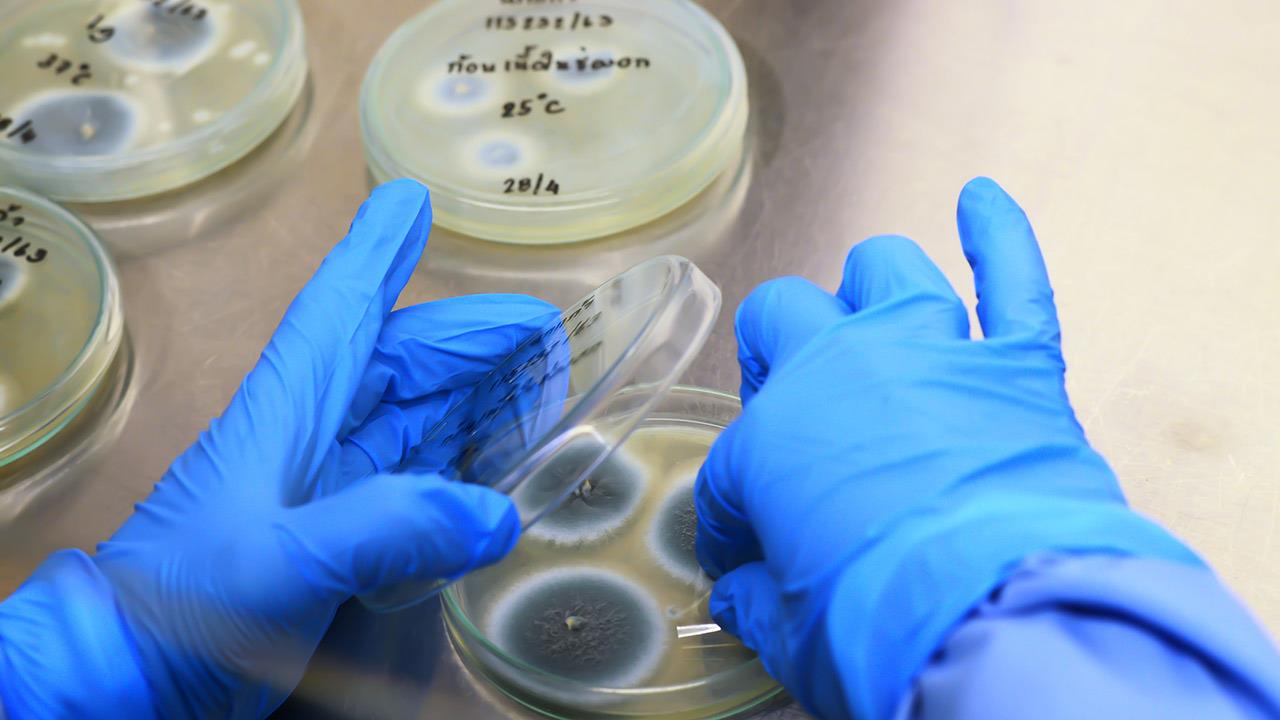

Σε τροχιά υλοποίησης εισέρχεται το εθνικό Δίκτυο Κέντρων Μαστού, μετά την εναρκτήρια συνάντηση για την ανάπτυξη ολοκληρωμένου συστήματος φροντίδας για τον καρκίνο του μαστού, που πραγματοποιήθηκε τη Δευτέρα 16 Φεβρουαρίου 2026 στο Αμφιθέατρο «ΣΟΦΙΑ ΜΠΕΦΟΝ» του Εθνικό Κέντρο Άμεσης Βοήθειας. Η Πράξη, η οποία χρηματοδοτείται από το Υπουργείο Υγείας, σηματοδοτεί την επίσημη έναρξη της συγκρότησης και λειτουργίας ενός δικτύου με κοινά πρότυπα ποιότητας, πιστοποίηση και ενιαία κλινικά μονοπάτια.
Τα νοσοκομεία που συγκροτούν τον βασικό πυρήνα του Δικτύου
Στο αρχικό σχήμα εντάσσονται το ΓΑΟΝΑ «Ο Άγιος Σάββας», το ΓΑΝΠ «Μεταξά», το ΑΝΘ «Θεαγένειο», το ΓΝΑ «Αλεξάνδρα» σε συνεργασία με το ΓΝΜ «Έλενα Βενιζέλου» και το ΓΟΝΚ «Οι Άγιοι Ανάργυροι». Πρόκειται για μονάδες που αναλαμβάνουν την ανάπτυξη και εφαρμογή προτύπων ποιότητας, καθώς και τη διαδικασία πιστοποίησης των Κέντρων Μαστού.
Εντός των επόμενων μηνών προβλέπεται η ένταξη και του ΓΝΑ «Ιπποκράτειο», διευρύνοντας τη γεωγραφική κάλυψη και τη λειτουργική επάρκεια του Δικτύου, με στόχο την ενιαία εφαρμογή υψηλών προδιαγραφών φροντίδας σε εθνικό επίπεδο.
Στρατηγική μεταρρύθμιση με επίκεντρο την ασθενή
Την έναρξη των εργασιών κήρυξε η διοικήτρια της 1ης Υγειονομικής Περιφέρειας και συντονίστρια του Δικτύου, Όλγα Μπαλαούρα, η οποία χαρακτήρισε την ανάπτυξη οργανωμένων και πιστοποιημένων Κέντρων Μαστού ως ουσιαστική μεταρρύθμιση με άμεσο αντίκτυπο στην επιβίωση, την ποιότητα ζωής και την εμπειρία των ασθενών. Έθεσε ως βασικές προϋποθέσεις τη θεσμοθέτηση σαφών ρόλων, τη λειτουργία Διεπιστημονικών Ομάδων, τη συστηματική καταγραφή και αξιολόγηση δεικτών ποιότητας και την καλλιέργεια κουλτούρας συνεχούς βελτίωσης.
Διαπεριφερειακή συνεργασία και πρόσβαση στις νησιωτικές περιοχές
Ο διοικητής της 2ης Υγειονομικής Περιφέρειας, Χρήστος Ροϊλός, υπογράμμισε ότι η οργανωμένη δικτύωση μπορεί να διασφαλίσει ισότιμη πρόσβαση στη φροντίδα, ιδιαίτερα για γυναίκες που διαμένουν σε νησιά. Όπως σημείωσε, η έγκαιρη διάγνωση, ο σαφής θεραπευτικός σχεδιασμός και η συντονισμένη παρακολούθηση αποτελούν κρίσιμες παραμέτρους για την αποφυγή καθυστερήσεων και κατακερματισμού των υπηρεσιών.
Θεσμικός ρόλος των ασθενών στη διαμόρφωση πολιτικών υγείας
Ιδιαίτερη βαρύτητα δόθηκε στη συμμετοχή των συλλόγων ασθενών. Ο πρόεδρος της Ελληνική Ομοσπονδία Καρκίνου, Γιώργος Καπετανάκης, ανέδειξε τη σημασία της ενεργού συμμετοχής των ασθενών στη χάραξη πολιτικών και στην αξιολόγηση των υπηρεσιών υγείας, επισημαίνοντας ότι η ποιότητα δεν αποτυπώνεται μόνο σε αριθμητικούς δείκτες αλλά και στη βιωμένη εμπειρία.
Από την πλευρά της, η πρόεδρος του Σύλλογος Γυναικών με Καρκίνο Μαστού «Άλμα Ζωής», Παρασκευή Μιχαλοπούλου, στάθηκε στον ρόλο της οργανωμένης κοινότητας στην πρόληψη, την ενημέρωση, την ψυχοκοινωνική στήριξη και την υπεράσπιση των δικαιωμάτων των γυναικών με καρκίνο του μαστού.
Ευρωπαϊκά πρότυπα, πιστοποίηση και δείκτες ποιότητας
Κατά τη διάρκεια της συνάντησης παρουσιάστηκαν το ευρωπαϊκό πλαίσιο πολιτικής για τον καρκίνο του μαστού, τα στάδια και οι απαιτήσεις πιστοποίησης, οι κρίσιμοι ρόλοι εντός των Κέντρων και το χρονοδιάγραμμα υλοποίησης. Έμφαση δόθηκε στη διακυβέρνηση του Δικτύου, στη διασφάλιση επάρκειας όγκου περιστατικών, στη λειτουργική ενσωμάτωση των Διεπιστημονικών Ομάδων και στη βιωσιμότητα της πιστοποίησης.
Η 1η Υγειονομική Περιφέρεια, ως συντονιστής του εγχειρήματος, σε συνεργασία με τα συμμετέχοντα νοσοκομεία και τους φορείς εκπροσώπησης ασθενών, προχωρά στην υλοποίηση ενός ενιαίου και πιστοποιημένου μοντέλου φροντίδας για τον καρκίνο του μαστού, με στόχο την αναβάθμιση της ογκολογικής περίθαλψης στη χώρα και τη διασφάλιση ποιοτικών, τεκμηριωμένων και διαφανών υπηρεσιών υγείας.
Διαβάστε επίσης
Προεγχειρητική βιοψία μαστού: Οι μύθοι και οι αλήθειες που σώζουν ζωές
Aνησυχία για την αύξηση καρκίνου του παχέος εντέρου, σε άτομα κάτω των 50 ετών